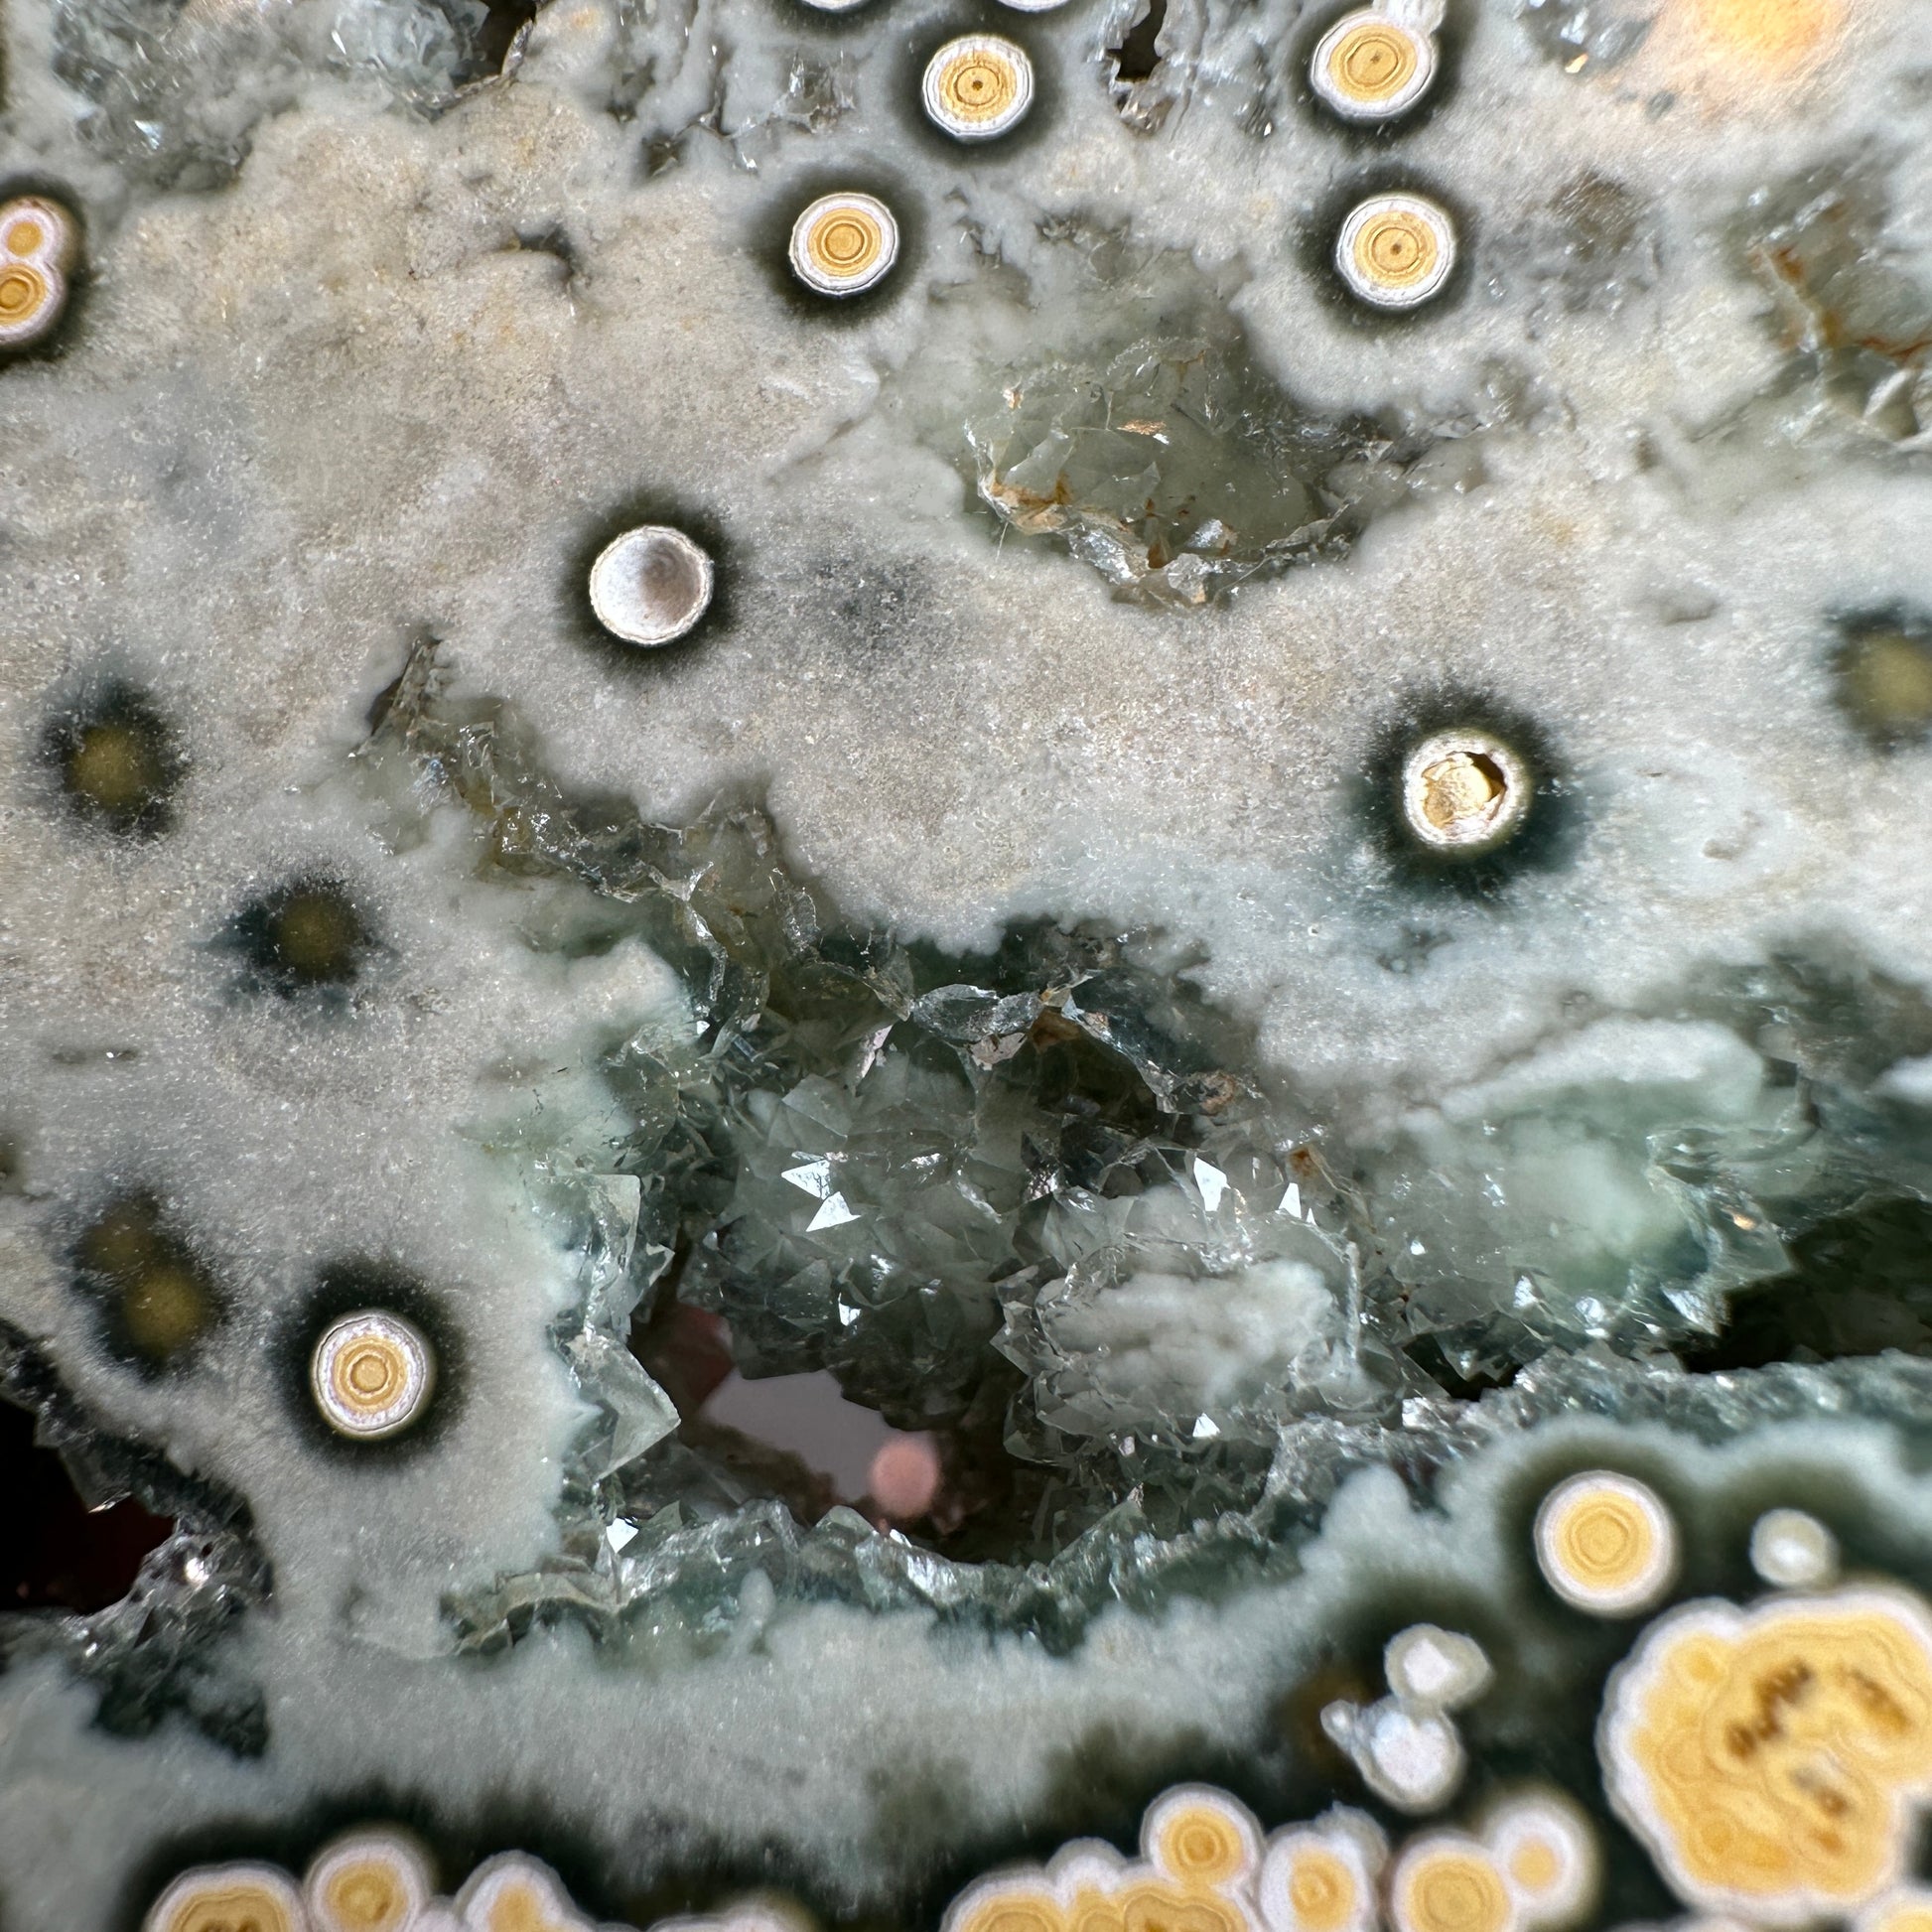

Mountain Jade
Natural Ocean Jasper Slab
Natural Ocean Jasper Slab
- Natural Ocean Jasper Slab
- Approximate Dimensions: 82,2 mm by 100.2 mm by 7.7 mm
- Approximate Weight: 153 g
- SKU: STS339
- It promotes emotional healing, inner peace, and spiritual growth. It enhances clarity, balance, and a deep connection with nature. Ocean Jasper is associated with grounding energy, encouraging self-expression, and facilitating personal growth. It brings joy, positivity, and a sense of tranquillity while stimulating creativity and intuition. Its unique patterns and colours are believed to resonate with the energy of the ocean and promote a harmonious state of being.
Politiques et clauses de non-responsabilité
Politiques et clauses de non-responsabilité
Toutes nos pierres et cristaux sont purs et naturels. Ils sont exempts de traitements synthétiques, notamment de colorants, de stabilisants et de traitements thermiques synthétiques pour rehausser la couleur.
Veuillez consulter notre politique de retour et d'échange avant de passer votre commande.
Veuillez nous contacter dans la Chatbox (coin inférieur droit) pour plus d'informations.
Politique d'expédition
Politique d'expédition
Canada : Livraison gratuite sur les commandes de plus de 200 $ CAD.
Dans le monde entier : livraison gratuite sur les commandes de plus de 300 $ CAD.
Les clients internationaux sont responsables de tous les frais de douane/taxes d’importation.
Instructions d'entretien
Instructions d'entretien
Protégez votre article des produits chimiques. Évitez tout contact avec des parfums et des lotions. Entreposer dans un endroit sec. Retirez-le avant de nager, de faire de l'exercice ou de prendre une douche.
1 en stock
Impossible de charger la disponibilité du service de retrait
Partager